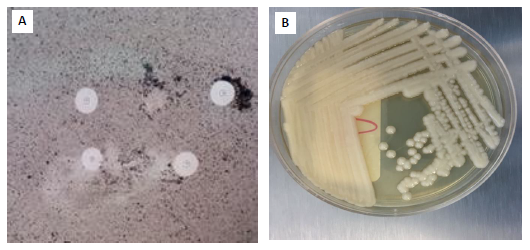

Introducción
Cryptococcosis is a fungal infection that is found all over the world and is caused primarily by Cryptococcus neoformans / Cryptococcus gattii (C. neoformans / C. gattii). C. neoformans primarily affects immunocompromised patients, whereas C. gattii affects immunocompetent patients exposed to the ecological niche of the fungus1.
Cryptococcosis is classified as an opportunistic infection because it typically manifests in patients with predisposing factors such as liver disease, kidney disease, sarcoidosis and other immunosuppressant conditions, particularly HIV infection2.
C. neoformans is the leading cause of meningitis in HIV patients, with an estimated incidence of 223,100 cases per year and an 81% mortality rate. Each year, approximately 5,300 HIV-infected individuals in Latin America are affected by cryptococcal meningitis, with a mortality rate ranging from 13 to 71%; Brazil and Colombia have the highest incidence in the region (1,001-2,500 cases), followed by Argentina and Mexico with 501-1,000 cases1.
Although cryptococcal infections in immunocompetent people are rare, there is growing interest in this patient population. According to reports, between 17 and 22% of diagnosed cases are from persons with "normal" immune function; however, some have been linked to primary or acquired immunodeficiency3,4. This article emphasizes the importance of considering Cryptococcus as an etiological agent in previously healthy individuals who require prompt diagnosis to improve their prognosis3.
Case description
A previously healthy 19-year-old woman was admitted to the emergency department after complaining of a headache, tinnitus, blurry vision and fever for 4 weeks. Two weeks prior, she had a medical appointment for the same symptoms, which were diagnosed as anxiety disorder; upon her return, additional symptoms of hallucinations and alterations in gait were noted. The patient denied alcohol, -or illicit drugs use-, and refused a previous medical history of unsafe sexual practices, recent travel, blood transfusion, animal contact, or being exposed to the ecological niche of the fungus.
She appeared to be ill. Her body temperature was 99.5oF (37.5oC), blood pressure was 120/60 mm/Hg, heart rate was 85 beats per minute, respiratory rate was 18 breaths per minute, and the pulse oximeter read 97% at room temperature. The patient appeared lethargic and confused. She had a normal cranial nerve examination, no Kerning's or Brudzinski's signs,
no neck stiffness, no motor weakness or cerebellar ataxia, normal and symmetrical tendon reflexes with no pathological reflexes, and no sensory impairment. The rest of the physical examination was normal. During her evaluation in the emergency department, she developed a generalized tonic-clonic seizure less than 1 minute (self-limited).
The white blood cell count was 10 x 103 /ml (5-12 x 103), with 81% neutrophils and 8% lymphocytes; hemoglobin level was 11.5 g/dL (normal values: 13-15.7)- and serum glucose level was 69 mg/dL. Other routine laboratory tests were normal. Additional laboratory and imaging studies were performed, including two HIV 1 and 2 tests using fourth generation ELISA serologies and viral load for HIV, both of which were negative.
A chest X-ray revealed a round lung lesion on the right middle lobe that suggested cavitation (figure 1A); chest computed tomography (CT) confirmed a right middle lobe peripheral cavitary lung lesion (figure 1B); and magnetic resonance imaging (MRI) of the brain revealed leptomeningeal enhancement (figures 1C and 1D).
Lumbar puncture yielded an opening cerebrospinal fluid (CSF) pressure of 13 cm H2O (12-15). The leukocyte count was 68 cells/ml, with 5% polymorphonuclear cells and 95% mononuclear cells, a total protein level of 150 mg/dl, a glucose level of 35 mg/dl (40-70), and a CSF/serum glucose ratio of 0.5. A cerebrospinal fluid polymerase chain cerebrospinal fluid polymerase chain (PCR) for herpes simplex virus type 1 and 2, varicella zoster virus, and cytomegalovirus was negative. A CSF GeneXpert Tb/Rif test was also negative, as were serum and cerebrospinal fluid Cryptococcal antigen latex agglutination tests.
On the India ink stain, encapsulated yeasts were compatible with Cryptococcus spp., and Cryptococcus neoformans var neoformans was isolated in Sabouraud dextrose agar cerebrospinal fluid culture (figure 2).
A video-assisted thoracoscopic surgery was performed, as well as a right lung biopsy (figure 3). The lung biopsy revealed non-caseous necrosis areas as well as a chronic inflammatory infiltrate containing spherical thick-walled microorganisms. Both PAS and mucicarmine stains confirmed round yeasts compatible with Cryptococcosis. Cryptococcus neoformans var neoformans was also isolated from lung tissue culture. A peripheral blood lymphocyte immunophenotype revealed a slight decrease in CD4+T cells (table 1), while serum immunoglobulins were normal.
The patient was diagnosed with disseminated cryptococcal disease and was treated for four weeks with liposomal amphotericin B 4 mg/kg IV QD (once a day) and fluconazole 800 mg IV QD, followed by fluconazole 400 mg QD maintenance therapy. She developed new onsets of altered mental status, headaches, meningismus, papilledema, hearing loss, and cranial nerve III and VI palsy shortly after switching to maintenance treatment. The intracranial pressure was noticeably elevated. Despite repeated lumbar punctures showing temporal improvement, a ventricular peritoneal shunt was required due to persistently high intracranial pressure. All her symptoms subsided, and she was discharged from the hospital asymptomatic. She continues the treatment phase with fluconazole 400 mg QD daily for the next 12 months.
Discussion
Disseminated cryptococcosis in immunocompetent individuals is uncommon. The lungs are the primary site of infection, and inoculation is usually via inhalation of yeast spores, with hematogenous spread mainly to the central nervous system5. Although the initial symptoms were from central nervous system involvement, a cavitary lesion at the lung level could be seen in this case. This radiological finding is unusual in immunocompetent patients, where non-calcified nodulation is more common in pulmonary cryptococcosis6.
The diagnosis of cryptococcal meningitis in immunocompetent hosts is diffcult and delays in diagnosis have been shown to have negative consequences for patients with a reported mortality rate of 9-27%. Due to brain-lung involvement, the diagnostic consideration was made in this case during the second admission and cryptococcus was actively searched for during the study. Although the changes in cerebrospinal fluid cytochemistry are indistinguishable from those seen in HIV patients8, some authors have suggested ruling out meningeal cryptococcosis when lymphocytosis is found in the cerebrospinal fluid in meningitis7.
In the diagnostic approach, the antigen test for cryptococcus has a sensitivity of 97% in cerebrospinal fluid and 87% in serum; false negatives have been described due to prozone effect, as may have occurred in this case; a negative test does not preclude diagnosis of cryptococcosis, particularly if only a single specimen has been tested and the patient exhibits symptoms consistent with cryptococcosis7,9. However, it has been shown that the India Ink of the cerebrospinal fluid has a 70-90% sensitivity in cryptococcal meningitis5.
The diagnosis of disseminated cryptococcosis is defined by the identification of the fungus in blood cultures or isolated in cultures from two sites. In this case, the fungus was identified in lung tissue and cerebrospinal fluid with the growth of Cryptococcus neoformans var neoformans. In addition, the gold standard in lung cryptococcosis demonstrated the presence of the fungus in biopsy10.
As recorded in outbreaks in Canada and the United States11 over the last decade, there has been an increase in cases of Cryptococcus infections in individuals without risk factors; this group may have subclinical innate or acquired immunodeficiencies.
Cryptococcus infections have been consistently reported in patients with idiopathic CD4 lymphopenia count below 200-100 cells/μl12. The absolute lymphocyte count in this patient was always abnormal, and a peripheral blood lymphocyte immunophenotype revealed a slight decrease in CD4+T cells; serum immunoglobulins were within normal limits and other acquired immunodeficiencies were ruled out. Other tests for the laboratory diagnosis of primary immunodeficiencies, such as flow cytometric-based assays to test immune cell function (neutrophil oxidative burst, NK cytotoxicity), intracellular cytokine production (TH17), cellular signaling pathways (phosphor-STAT analysis), and protein expression (BTK, Foxp3)13-15, are not available in our institution.
In this group of otherwise normal patients, the outcomes and complications may be more severe, including more likely permanent neurologic sequelae such as stroke, blindness, deafness, and other focal cranial nerve abnormalities7,13. Some studies have suggested that immunocompetent individuals develop post-infectious inflammatory response syndrome (PIIRS), a paradoxical worsening of symptoms caused by immune dysregulation or aberrant immune control, like immune reconstitution syndrome (IRIS) in patients with HIV infection, after the start of antiretroviral therapy5,14,15.
In both cryptococcal meningitis IRIS and PIIRS, there is activation of the dendritic T-cells of the synapse and an increase in IFN-γ and IL-6 cytokines in response to T-cell activation; however, PIIRS lacks effective macrophage activation. This macrophage dissociation -T cell leads to the persistence of tissue antigen, which perpetuates the inflammatory response, resulting in clinical deterioration despite adequate antifungal therapy5.
This case teaches that disseminated cryptococcal infection in immunocompetent patients is uncommon, can manifest in a variety of clinical presentations and innate or acquired immunodeficiencies must be ruled out.